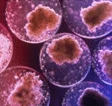
Usa, cellule staminali umane

E negli Usa viene dato definitivamente il via allo stanziamento di fondi pubblici per la ricerca sulle staminali. Obama lo aveva promesso in campagna elettorale, dopo che per otto anni questo tipo di studi erano stati impediti dall'allora presidente George Bush. Nessuna sorpresda, dunque, per l'ok ai fondi pubblici per la ricerca su 13 linee dicellule staminali embrionali umane, create - grazie a donazioni private- dagli scienziati della Harvard University di Cambridge e dellaRockefeller University di New York.